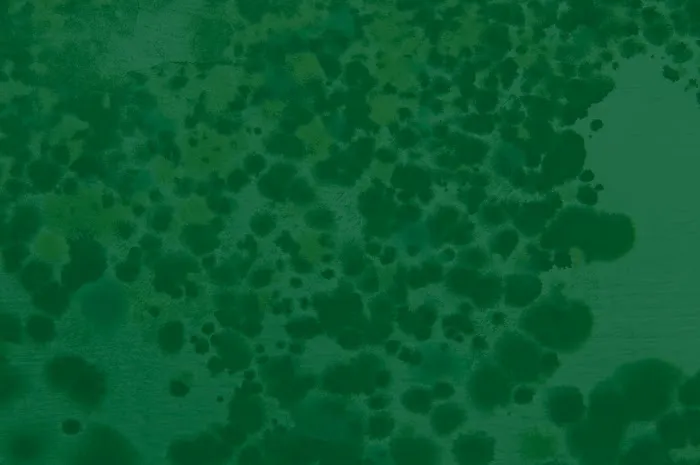
Northwest Emergency Services Picture 5

Northwest Emergency Services Photos

Northwest Emergency Services Introduce
Introduction / Overview
For homeowners, property managers, and business owners across the West Sound area, including Kitsap and Pierce Counties in Washington, unexpected property damage is an unavoidable reality. When disaster strikes—whether it’s a sudden flood from a burst pipe, severe smoke damage from a fire, or insidious mold growth—you need more than just a repair company; you need a single, reliable partner to handle the entire recovery process. This is where **Northwest Emergency Services** steps in. Operating as a licensed, bonded, and fully insured general contractor, this Bremerton-based firm specializes in end-to-end disaster restoration, building restoration, and remodeling services.
Northwest Emergency Services is fundamentally an emergency response organization, offering services around the clock to mitigate damage immediately and begin the path toward recovery. Their comprehensive approach ensures that they manage the project from the initial emergency water extraction and cleanup to the final coat of paint and installation of new flooring. Their goal is not just to fix the damage, but to fully restore the property—and the peace of mind—of their clients. The company is known throughout the local community for its rapid response time and quality service, handling both residential and commercial projects, even those involving complex insurance claims.
The local expertise of the Northwest Emergency Services team is a major asset. With deep knowledge of the specific challenges posed by the Pacific Northwest climate, from high moisture levels leading to mold to storm damage common along the coast, they employ targeted strategies and advanced equipment to ensure thorough and lasting restoration results.
Location and Accessibility
Strategic location is paramount for an emergency response service. Northwest Emergency Services is headquartered at **865 6th St UNIT 300, Bremerton, WA 98337, USA**. This central Bremerton location places them within quick striking distance of key communities in Kitsap County, including Port Orchard, Silverdale, and Poulsbo, while also providing efficient access to major routes for serving Pierce County and the broader West Sound area.
Understanding that an emergency can happen at any time, the firm operates with a **24-hour availability**, every day of the year. This crucial commitment to round-the-clock service ensures that when water is flooding a basement or fire damage is still smoking, a professional crew is en route immediately. Furthermore, their physical facility demonstrates a commitment to community accessibility, featuring both a **Wheelchair accessible entrance** and a **Wheelchair accessible parking lot**.
Contact Information
For immediate emergency assistance or to schedule an inspection for remodeling or repairs, the team at Northwest Emergency Services is available via the following contact channels:
Address: 865 6th St UNIT 300, Bremerton, WA 98337, USA
Phone (24/7 Emergency): (360) 692-9111
Mobile Phone: +1 360-692-9111
Services Offered
Northwest Emergency Services offers a comprehensive suite of services, uniquely combining disaster mitigation with full general contracting capabilities. This allows for an unparalleled "remediation and rebuild" experience for Washington clients.
Emergency Water Damage Mitigation: This is a core 24/7 service, including **Emergency Water Extraction**, **Drying Equipment** setup (Air Movers, Air Scrubbers, Negative Air Machines), **Moisture Detection**, **Custom Drying** solutions like **Hardwood Floor Drying**, and final sanitizing and disinfecting.
Mold Remediation and Inspection: Full-service mold management, including detailed **Mold Inspection**, professional **Mold Removal**, **Mold Cleaning**, and tackling any existing **Mold Problem** stemming from water damage, ensuring safe and thorough remediation.
Fire and Smoke Damage Restoration: Services include **Fire damage cleanup & repair**, as well as specialized **Smoke Odor Removal** and structural cleanup to prepare the area for reconstruction.
General Contracting and Reconstruction: As a licensed general contractor, they handle the **Total Reconstruction** required after a loss. This includes all aspects of the rebuild: **Remodeling**, **Drywall installation** and **Drywall repair**, **Install flooring** and **Repair flooring**, **Exterior painting**, **Paint indoors**, and general **Construction And Repairs**.
Specialized Cleanup Services: Expert handling of hazardous situations, including **Sewage cleanup**, **Biohazard Remediation**, and **Blood Cleaning**, performed with strict adherence to safety and health standards.
Carpet and Upholstery Cleaning: Beyond disaster cleanup, they offer regular maintenance services such as **General carpet cleaning**, detailed **Area rug cleaning**, **Upholstery cleaning**, and focused treatment for **Pet stain & odor removal**.
Features / Highlights
What makes Northwest Emergency Services the preferred contractor in the West Sound region is a combination of certifications, technology, and customer-focused practices:
Licensed General Contractor for Total Reconstruction: Their certification as a general contractor allows them to complete the entire restoration project, from the initial "Tear Out" and emergency mitigation to the "Total Reconstruction" and final interior painting, eliminating the stress of managing multiple contractors.
24/7/365 Emergency Service: The team is on call around the clock, providing a vital, rapid response capability that minimizes damage and saves Washington property owners significant time and money.
Insurance Advocacy and Free Estimates: The firm is highly experienced in working with **Homeowner's Insurance** and directly handling **Insurance Billing**. Their representative, as noted by one client, "worked directly with my Property Management and insurance and advocated on my behalf," providing detailed reports and precise photos to streamline the claims process.
Advanced Diagnostic Equipment: They utilize cutting-edge tools to ensure nothing is missed, including **Thermal Imaging Cameras** for precise **Moisture Detection** and industrial-grade **Hepa Filters** and **Air Scrubbers** to manage air quality during remediation.
Commercial and Residential Capacity: Equipped and staffed to handle disasters of any scale, from a small flooded basement in a home to large-scale **Commercial Project** losses, including places of worship, as evidenced by a thankful review.
Commitment to Customer Service: Reviewers consistently highlight the team's professionalism, courtesy, and adaptability to individual client needs, demonstrating a commitment to service that transcends simply completing the technical work.
What is worth choosing
When facing a property emergency in Kitsap or Pierce County, choosing Northwest Emergency Services is a decision to prioritize professionalism, speed, and completeness. What truly sets them apart and makes them the worthwhile choice for Washington property owners is their ability to deliver a seamless, integrated, and fully supported restoration journey.
Unlike specialized cleanup services that leave homeowners to find a separate general contractor for the rebuild, Northwest Emergency Services offers a single point of contact for the entire "Remediation And Rebuild" process. This "end-to-end client experience," as they call it, ensures communication is seamless, budgeting is controlled, and the quality of the final construction is assured. The complexity of projects involving water, fire, and mold damage demands this level of comprehensive project management. Their expertise in the often-tricky world of insurance claims—actively advocating for the client and providing "detailed and precise" documentation—adds a layer of financial protection that is invaluable during a crisis.
Furthermore, their specialization in mold remediation and sewage cleanup, backed by the use of advanced equipment like **Negative Air Machines** and a strong focus on sanitizing and disinfecting, is crucial for maintaining a healthy indoor environment in the moist Washington climate. For a local contractor known for its integrity, rapid response, and the technical skill to "Fully Restore" any property, Northwest Emergency Services in Bremerton stands out as the trusted choice for emergency and reconstruction needs.
Northwest Emergency Services Services
Carpet Cleaning Service
- Area rug cleaning
- General carpet cleaning
- Pet stain & odor removal
- Upholstery cleaning
General Contractor
- Drywall installation
- Drywall repair
- Exterior painting
- Install flooring
- Paint indoors
- Remodeling
- Repair flooring
Water Damage Restoration Service
- Fire damage cleanup & repair
- Flooring
- Mold inspection
- Painting
- Plumbing
- Sewage cleanup
- Water damage-related cleanup & repair
- Water damage-related mold removal
- Air Movers
- Air Scrubbers
- Area Rugs
- Biohazard Remediation
- Blood Cleaning
- Carpet Cleaning
- Clean Up
- Commercial Project
- Construction And Repairs
- Custom Drying
- Drying Equipment
- Drying Systems
- Emergency Mitigation
- Emergency Water Extraction
- Emergency Water Mitigation
- Free Estimates
- Fully Restore
- General Contractors
- Hardwood Floor Drying
- Hepa Filters
- Home Water Damage
- Homeowner's Insurance
- Insurance Billing
- Leak Detection
- Local Restoration
- Moisture Detection
- Mold Cleaning
- Mold Problem
- Mold Remediation Cost
- Mold Removal
- Negative Air Machines
- New Construction
- Offer Superior Restoration Service
- Property Maintenance
- Remediation And Rebuild
- Residential And Commercial Restoration
- Restoration Estimate
- Sanitizing And Disinfecting
- Smoke Odor Removal
- Special Drying
- Tear Out
- Thermal Imaging Cameras
- Total Reconstruction
- Water Damage Repairs
- Water Extraction And Drying
- Water/Flood Damage
Northwest Emergency Services Details
Accessibility
- Wheelchair accessible entrance
- Wheelchair accessible parking lot
Northwest Emergency Services Location
Northwest Emergency Services
865 6th St UNIT 300, Bremerton, WA 98337, USA
Northwest Emergency Services Reviews
INSURANCEcompanyjobfebruaryAPPLIANCES2022cabinetspaycontractorsproject
★ 5★ 4★ 3★ 2★ 1Jacks crew was professional and adaptable to my needs. Without Northwest Restoration and their advice this insurance project would have taken longer than it did. I’ve learned yet again that patience and common courtesy works way better than complaining. Although that team definitely got an earful from me their resilience to my needs superseded my whining. Thanks guys!
Jul 17, 2024 · Joanne CollensNW Restoration & Emergency Services provided an excellent job for handling water mitigation at my rental property when my tenant’s washer sensor broke and flooded the entire basement. NW Restoration were thorough and consistent with the work ensuring timeliness and safety. The staff are courteous and Rich Ray, the representative handling the case, worked directly with my Property Management and insurance and advocated on my behalf. The reports and photos provided to my insurance company were detailed and precise. Thank you for the job well done!
Feb 25, 2025 · Mari AcostaNorthwest Restoration helped us when a fire sprinkler pipe burst and flooded several rooms in our church, including the sanctuary. We were so grateful for their rapid response and professional service!
Jul 15, 2024 · Rev. Hillary KimseyI had a leak in my coffee stand and Rich from Northwest Restoration and Emergency services came back the same day and helped me find the leak they are family friendly and will get the job done.
Aug 01, 2025 · Ali BrownRich Ray with Northwest Restoration did a great job of working with my insurance to get the repairs done for my house that flooded from an upstairs bathroom. He coordinated well with me, the owner, when needed for input on the repairs and his team did a quality job in a timely manner.
Aug 17, 2024 · Joanne Crompton
More Water Damage Restoration Near Me
 Roto-Rooter Plumbing & Water Cleanup4.0 (211 reviews)
Roto-Rooter Plumbing & Water Cleanup4.0 (211 reviews)423 Pacific Ave suite 303, Bremerton, WA 98337, USA
 Northwest Crawl Space Services5.0 (25 reviews)
Northwest Crawl Space Services5.0 (25 reviews)509 4th St Suite 17, Bremerton, WA 98337, USA
 Crane Water Damage Restoration Experts5.0 (6 reviews)
Crane Water Damage Restoration Experts5.0 (6 reviews)1700 SE Mile Hill Dr suite 146, Port Orchard, WA 98366, USA
 SERVPRO of Kitsap County4.0 (66 reviews)
SERVPRO of Kitsap County4.0 (66 reviews)3439 WA-3, Bremerton, WA 98312, USA
 Barnes Emergency Water Damage Restoration5.0 (23 reviews)
Barnes Emergency Water Damage Restoration5.0 (23 reviews)10049 Kitsap Mall Blvd NW suite 578, Silverdale, WA 98383, USA
 Paul Davis of the Olympic Peninsula4.0 (39 reviews)
Paul Davis of the Olympic Peninsula4.0 (39 reviews)5538 Cruiser Loop SW, Bremerton, WA 98312, USA
 Roto-Rooter Plumbing & Water Cleanup4.0 (249 reviews)
Roto-Rooter Plumbing & Water Cleanup4.0 (249 reviews)1040 NE Hostmark St B002, Poulsbo, WA 98370, USA
 Hadley Water Damage Restoration0.0 (0 reviews)
Hadley Water Damage Restoration0.0 (0 reviews)19735 10th Ave NE suite 127, Poulsbo, WA 98370, USA
 SERVPRO of Gig Harbor / North Tacoma and Mason County4.0 (32 reviews)
SERVPRO of Gig Harbor / North Tacoma and Mason County4.0 (32 reviews)10421 Burnham Dr Bldg 2, Gig Harbor, WA 98335, USA
 Stanley Steemer4.0 (432 reviews)
Stanley Steemer4.0 (432 reviews)26262 Lindvog Rd NE Ste 130 & 140, Kingston, WA 98346, USA
 Roto-Rooter Plumbing & Water Cleanup4.0 (160 reviews)
Roto-Rooter Plumbing & Water Cleanup4.0 (160 reviews)2801 Hollycroft St Ste 10-B, Gig Harbor, WA 98335, USA
 Nordic Properties and Insulation LLC5.0 (23 reviews)
Nordic Properties and Insulation LLC5.0 (23 reviews)28663 Hansville Rd NE, Kingston, WA 98346, USA
Categories
Top Visited Sites
 Restoration 1 of Chester County5.0 (79 reviews)
Restoration 1 of Chester County5.0 (79 reviews) J Brian Day Emergency Service4.0 (121 reviews)
J Brian Day Emergency Service4.0 (121 reviews) Father and Son restoration & mitigation5.0 (6 reviews)
Father and Son restoration & mitigation5.0 (6 reviews) Paul Davis Restoration of Lynchburg, Roanoke & Southside VA5.0 (18 reviews)
Paul Davis Restoration of Lynchburg, Roanoke & Southside VA5.0 (18 reviews) Poblano Cleaning & Restoration Services4.0 (27 reviews)
Poblano Cleaning & Restoration Services4.0 (27 reviews) Environmental Solutions5.0 (8 reviews)
Environmental Solutions5.0 (8 reviews)Top Searches
Trending Damage Repair Guides Posts
 Water Damage Repair for Subflooring Under Carpets
Water Damage Repair for Subflooring Under Carpets How to Handle Water Damage After a Storm: A Step-by-Step Guide
How to Handle Water Damage After a Storm: A Step-by-Step Guide Water Damage Restoration for Restaurants and Food Service Areas – A Complete Guide
Water Damage Restoration for Restaurants and Food Service Areas – A Complete Guide How to Deal With Water Damage From Roof Ice Dams: Prevention and Repair Tips
How to Deal With Water Damage From Roof Ice Dams: Prevention and Repair Tips What to Do if Your Roof Is Leaking and Causing Water Damage Inside
What to Do if Your Roof Is Leaking and Causing Water Damage Inside How to Restore Water-Damaged Rugs and Carpets
How to Restore Water-Damaged Rugs and Carpets 
